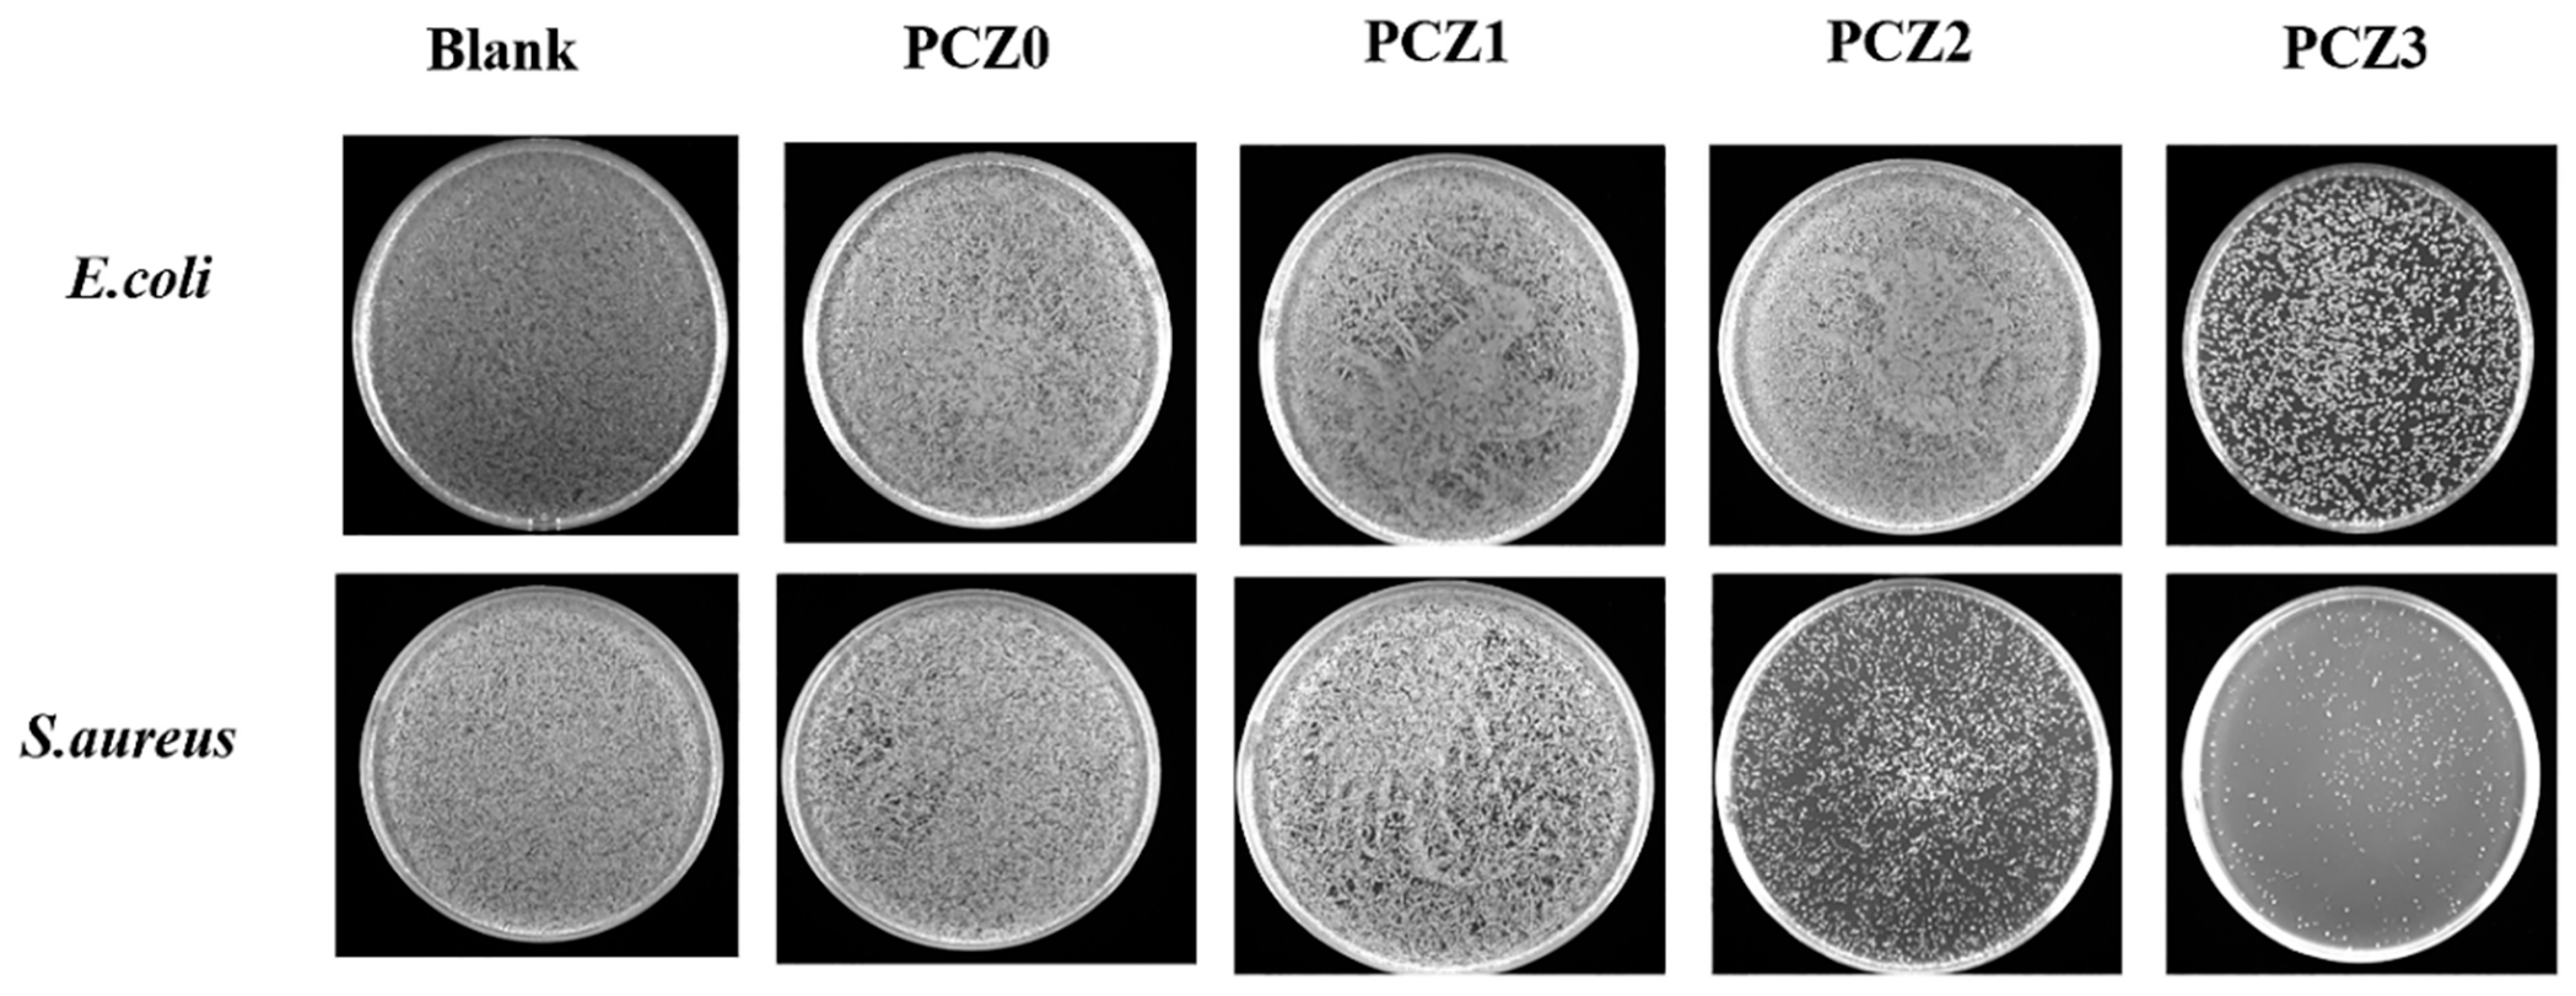
Gels 08 00279 g007 550

In Situ Growth of Zeolitic Imidazolate Framework-L in Macroporous PVA/CMC/PEG Composite Hydrogels with Synergistic Antibacterial and Rapid Hemostatic Functions for Wound Dressing
Abstract
:1. Introduction
2. Results and Discussion
2.1. Structure Analysis
2.2. Zinc Ion Release
2.3. Biocompatibility Analysis
2.4. Hemostatic Analysis
2.5. In Vitro Antibacterial Assays
3. Conclusions
4. Experimental Section
4.1. Materials
4.2. Preparation of PVA/CMC/PEG Composite Hydrogel
4.3. In Situ Growth of ZIF-L on PVA/CMC/PEG Composite Hydrogel
4.4. Testing and Characterization
4.4.1. Scanning Electron Microscopy (SEM)
4.4.2. Fourier Transform Infrared Spectroscopy (FTIR)
4.4.3. X-ray Diffraction (XRD)
4.4.4. Zinc Ion Release
4.4.5. Biocompatibility Test
4.4.6. In Vitro Coagulation Test
4.4.7. In Vivo Hemostasis Test
4.4.8. In Vitro Antibacterial Test
4.4.9. Statistical Analysis
Author Contributions
Funding
Institutional Review Board Statement
Informed Consent Statement
Data Availability Statement
Acknowledgments
Conflicts of Interest
References
- Wang, Y.; Fu, Y.; Li, J.; Mu, Y.; Zhang, X.; Zhang, K.; Liang, M.; Feng, C.; Chen, X. Multifunctional chitosan/dopamine/diatom-biosilica composite beads for rapid blood coagulation. Carbohydr. Polym. 2018, 200, 6–14. [Google Scholar] [CrossRef]
- Zhao, X.; Guo, B.; Hao, W.; Liang, Y.; Ma, P.X. Injectable antibacterial conductive nanocomposite cryogels with rapid shape recovery for noncompressible hemorrhage and wound healing. Nat. Commun. 2018, 9, 1–17. [Google Scholar] [CrossRef] [PubMed] [Green Version]
- Feng, Y.; Wang, Q.; He, M.; Zhao, W.; Zhao, C. Nonadherent Zwitterionic Composite Nanofibrous Membrane with Halloysite Nanocarrier for Sustained Wound Anti-Infection and Cutaneous Regeneration. ACS Biomater. Sci. Eng. 2019, 6, 621–633. [Google Scholar] [CrossRef] [PubMed]
- Liu, M.; Wang, X.; Li, H.; Xia, C.; Wu, J. Magnesium oxide incorporated electrospun membranes inhibit bacterial infections and promote healing process of infected wounds. J. Mater. Chem. B 2021, 9, 3727–3744. [Google Scholar] [CrossRef]
- Zhang, L.; Liu, M.; Zhang, Y.; Pei, R. Recent Progress of Highly Adhesive Hydrogels as Wound Dressings. Biomacromolecules 2020, 21, 3966–3983. [Google Scholar] [CrossRef]
- Kozen, B.G.; Kircher, S.J.; Henao, J.; Godinez, F.S.; Johnson, A.S. An Alternative Hemostatic Dressing: Comparison of CELOX, HemCon, and QuikClot. Acad. Emerg. Med. 2014, 15, 74–81. [Google Scholar] [CrossRef] [PubMed]
- Pourshahrestani, S.; Zeimaran, E.; Kadri, N.A.; Gargiulo, N.; Samuel, S.; Naveen, S.V.; Kamarul, T.; Towler, M.R. Gallium-Containing mesoporous bioactive glass with potent hemostatic activity and antibacterial efficacy. J. Mater. Chem. B. Mater. Biol. Med. 2016, 4, 71–86. [Google Scholar] [CrossRef] [PubMed]
- Quan, C.; Zhang, L.; Gao, Y.; Tang, P. Research progress of antibacterial hydrogel dressings. Acad. J. Chin. PLA Med. Sch. 2017, 38, 4. [Google Scholar]
- Deng, Z.; Guo, Y.; Zhao, X.; Ma, P.X.; Guo, B. Multifunctional Stimuli-Responsive Hydrogels with Self-Healing, High Conductivity, and Rapid Recovery through Host-Guest Interactions. Chem. Mater. A Publ. Am. Chem. Soc. 2018, 30, 1729–1742. [Google Scholar] [CrossRef]
- Gan, D.; Xing, W.; Jiang, L.; Fang, J.; Zhao, C.; Ren, F.; Fang, L.; Wang, K.; Lu, X. Plant-inspired adhesive and tough hydrogel based on Ag-Lignin nanoparticles-triggered dynamic redox catechol chemistry. Nat. Commun. 2019, 10, 1–10. [Google Scholar] [CrossRef] [Green Version]
- Zhong, Y.; Xiao, H.; Seidi, F.; Jin, Y. Natural Polymer-Based Antimicrobial Hydrogels without Synthetic Antibiotics as Wound Dressings. Biomacromolecules 2020, 21, 2983–3006. [Google Scholar] [CrossRef]
- Mirean, V. Current Trends in Advanced Alginate-Based Wound Dressings for Chronic Wounds. J. Pers. Med. 2021, 11, 890. [Google Scholar]
- Barbu, A.; Neamu, M.B.; Zhan, M.; Mirean, V. Trends in alginate-based films and membranes for wound healing. Rom. Biotechnol. Lett. 2020, 25, 1683–1689. [Google Scholar]
- Sharma, S.; Kumar, R.; Kumari, P.; Kharwar, R.N.; Yadav, A.K.; Saripella, S. Mechanically magnified chitosan-based hydrogel as tissue adhesive and antimicrobial candidate. Int. J. Biol. Macromol. 2018, 125, 109–115. [Google Scholar] [CrossRef] [PubMed]
- Lotfipour, F.; Alami-Milani, M.; Salatin, S.; Hadavi, A.; Jelvehgari, M. Freeze-Thaw-Induced cross-linked PVA/chitosan for oxytetracycline-loaded wound dressing: The experimental design and optimization. Res. Pharm. Sci. 2019, 14, 175. [Google Scholar]
- Chaudhuri, B.; Mondal, B.; Ray, S.K.; Sarkar, S.C. A novel biocompatible conducting polyvinyl alcohol (PVA)-polyvinylpyrrolidone (PVP)-hydroxyapatite (HAP) composite scaffolds for probable biological application. Colloids Surf. B Biointerfaces 2016, 143, 71–80. [Google Scholar] [CrossRef]
- Chuenbarn, T.; Sirirak, J.; Tuntarawongsa, S.; Okonogi, S.; Phaechamud, T. Design and Comparative Evaluation of Vancomycin HCl-Loaded Rosin-Based In Situ Forming Gel and Microparticles. Gels 2022, 8, 231. [Google Scholar] [CrossRef]
- Posadowska, U.; Brzychczy-Włoch, M.; Drożdż, A.; Krok-Borkowicz, M.; Włodarczyk-Biegun, M.; Dobrzyński, P.; Chrzanowski, W.; Pamuła, E. Injectable hybrid delivery system composed of gellan gum, nanoparticles and gentamicin for the localized treatment of bone infections. Expert Opin. Drug Deliv. 2016, 13, 613–620. [Google Scholar] [CrossRef]
- Carpa, R.; Remizovschi, A.; Culda, C.A.; Butiuc-Keul, A.L. Inherent and Composite Hydrogels as Promising Materials to Limit Antimicrobial Resistance. Gels 2022, 8, 70. [Google Scholar] [CrossRef]
- Li, S.; Dong, S.; Xu, W.; Tu, S.; Yan, L.; Zhao, C.; Ding, J.; Chen, X. Antibacterial hydrogels. Adv. Sci. 2018, 5, 1700527. [Google Scholar] [CrossRef] [Green Version]
- Han, D.; Li, Y.; Liu, X.; Li, B.; Han, Y.; Zheng, Y.; Yeung, K.W.K.; Li, C.; Cui, Z.; Liang, Y. Rapid bacteria trapping and killing of metal-organic frameworks strengthened photo-responsive hydrogel for rapid tissue repair of bacterial infected wounds. Chem. Eng. J. 2020, 396, 125194. [Google Scholar] [CrossRef]
- Hou, S.; Liu, Y.; Feng, F.; Zhou, J.; Feng, X.; Fan, Y. Polysaccharide-Peptide Cryogels for Multidrug-Resistant-Bacteria Infected Wound Healing and Hemostasis. Adv. Healthc. Mater. 2020, 9, 1901041. [Google Scholar] [CrossRef]
- Shi, Y.; Li, D.; Ding, J.; He, C.; Chen, X. Physiologically relevant pH-and temperature-responsive polypeptide hydrogels with adhesive properties. Polym. Chem. 2021, 12, 2832–2839. [Google Scholar] [CrossRef]
- Wan, Y.; Liu, L.; Yuan, S.; Sun, J.; Li, Z. pH-Responsive peptide supramolecular hydrogels with antibacterial activity. Langmuir 2017, 33, 3234–3240. [Google Scholar] [CrossRef] [PubMed]
- Jing, J.; Liang, S.; Yan, Y.; Tian, X.; Li, X. Fabrication of hybrid hydrogels from silk fibroin and tannic acid with enhanced gelation and antibacterial activities. ACS Biomater. Sci. Eng. 2019, 5, 4601–4611. [Google Scholar] [CrossRef] [PubMed]
- Yang, W.; Fortunati, E.; Bertoglio, F.; Owczarek, J.; Bruni, G.; Kozanecki, M.; Kenny, J.; Torre, L.; Visai, L.; Puglia, D. Polyvinyl alcohol/chitosan hydrogels with enhanced antioxidant and antibacterial properties induced by lignin nanoparticles. Carbohydr. Polym. 2018, 181, 275–284. [Google Scholar] [CrossRef] [PubMed]
- Li, Z.; Chen, S.; Wu, B.; Liu, Z.; Cheng, L.; Bao, Y.; Ma, Y.; Chen, L.; Tong, X.; Dai, F. Multifunctional dual ionic-covalent membranes for wound healing. ACS Biomater. Sci. Eng. 2020, 6, 6949–6960. [Google Scholar] [CrossRef] [PubMed]
- Dacrory, S.; Abou-Yousef, H.; Abouzeid, R.E.; Kamel, S.; Abdel-Aziz, M.S.; El-Badry, M. Antimicrobial cellulosic hydrogel from olive oil industrial residue. Int. J. Biol. Macromol. 2018, 117, 179–188. [Google Scholar] [CrossRef]
- Dai, C.; Zhou, Z.; Guan, Z.; Wu, Y.; Liu, Y.; He, J.; Yu, P.; Tu, L.; Zhang, F.; Chen, D. A Multifunctional Metallohydrogel with Injectability, Self-Healing, and Multistimulus-Responsiveness for Bioadhesives. Macromol. Mater. Eng. 2018, 303, 1800305. [Google Scholar] [CrossRef]
- Li, P.; Li, J.; Feng, X.; Li, J.; Hao, Y.; Zhang, J.; Wang, H.; Yin, A.; Zhou, J.; Ma, X. Metal-Organic frameworks with photocatalytic bactericidal activity for integrated air cleaning. Nat. Commun. 2019, 10, 2177. [Google Scholar] [CrossRef]
- Tubek, S.; Grzanka, P.; Tubek, I. Role of zinc in hemostasis: A review. Biol. Trace Elem. Res. 2008, 121, 1–8. [Google Scholar] [CrossRef] [PubMed]
- Davidson-Rozenfeld, G.; Stricker, L.; Simke, J.; Fadeev, M.; Vázquez-González, M.; Ravoo, B.J.; Willner, I. Light-responsive arylazopyrazole-based hydrogels: Their applications as shape-memory materials, self-healing matrices and controlled drug release systems. Polym. Chem. 2019, 10, 4106–4115. [Google Scholar] [CrossRef]
- Fan, X.; Yang, F.; Huang, J.; Yang, Y.; Nie, C.; Zhao, W.; Ma, L.; Cheng, C.; Zhao, C.; Haag, R. Metal–organic-framework-derived 2D carbon nanosheets for localized multiple bacterial eradication and augmented anti-infective therapy. Nano Lett. 2019, 19, 5885–5896. [Google Scholar] [CrossRef] [PubMed]
- Liang, Y.; Wang, M.; Zhang, Z.; Ren, G.; Liu, Y.; Wu, S.; Shen, J. Facile synthesis of ZnO QDs@ GO-CS hydrogel for synergetic antibacterial applications and enhanced wound healing. Chem. Eng. J. 2019, 378, 122043. [Google Scholar] [CrossRef]
- Liang, Y.; Zhao, X.; Hu, T.; Chen, B.; Yin, Z.; Ma, P.X.; Guo, B. Adhesive hemostatic conducting injectable composite hydrogels with sustained drug release and photothermal antibacterial activity to promote full-thickness skin regeneration during wound healing. Small 2019, 15, 1900046. [Google Scholar] [CrossRef]
- Patra, P.; Rameshbabu, A.P.; Das, D.; Dhara, S.; Panda, A.B.; Pal, S. Stimuli-responsive, biocompatible hydrogel derived from glycogen and poly (N-isopropylacrylamide) for colon targeted delivery of ornidazole and 5-amino salicylic acid. Polym. Chem. 2016, 7, 5426–5435. [Google Scholar] [CrossRef]
- Joorabloo, A.; Khorasani, M.T.; Adeli, H.; Mansoori-Moghadam, Z.; Moghaddam, A. Fabrication of heparinized nano ZnO/poly (vinylalcohol)/carboxymethyl cellulose bionanocomposite hydrogels using artificial neural network for wound dressing application. J. Ind. Eng. Chem. 2019, 70, 253–263. [Google Scholar] [CrossRef]
- Winter, G.D. Formation of the scab and the rate of epithelization of superficial wounds in the skin of the young domestic pig. Nature 1962, 193, 293–294. [Google Scholar] [CrossRef]
- Gao, L.; Zhang, H.; Yu, B.; Li, W.L.; Cong, H. Chitosan composite hydrogels cross-linked by multifunctional diazo resin as antibacterial dressings for improved wound healing. J. Biomed. Mater. Res. Part A 2020, 108, 1890–1898. [Google Scholar] [CrossRef]
- Jiao, C.; Gao, L.; Zhang, H.; Yu, B.; Shen, Y. Dynamic covalent C=C bond crosslinked injectable and self-healable hydrogels via Knoevenagel condensation. Biomacromolecules 2020, 21, 1234–1242. [Google Scholar] [CrossRef]
- Chen, R.; Yao, J.; Gu, Q.; Smeets, S.; Baerlocher, C.; Gu, H.; Zhu, D.; Morris, W.; Yaghi, O.M.; Wang, H. A two-dimensional zeolitic imidazolate framework with a cushion-shaped cavity for CO 2 adsorption. Chem. Commun. 2013, 49, 9500–9502. [Google Scholar] [CrossRef] [PubMed]
- Zhang, J.; Zhang, T.; Yu, D.; Xiao, K.; Hong, Y. Transition from ZIF-L-Co to ZIF-67: A new insight into the structural evolution of zeolitic imidazolate frameworks (ZIFs) in aqueous systems. CrystEngComm 2015, 17, 8212–8215. [Google Scholar] [CrossRef]
- Zhao, H.; Feng, Y.; Guo, J. Grafting of poly (ethylene glycol) monoacrylate onto polycarbonateurethane surfaces by ultraviolet radiation grafting polymerization to control hydrophilicity. J. Appl. Polym. Sci. 2011, 119, 3717–3727. [Google Scholar] [CrossRef]
- Li, Y.; Zhu, C.; Fan, D.; Fu, R.; Ma, P.; Duan, Z.; Li, X.; Lei, H.; Chi, L. Construction of porous sponge-like PVA-CMC-PEG hydrogels with pH-sensitivity via phase separation for wound dressing. Int. J. Polym. Mater. Polym. Biomater. 2020, 69, 505–515. [Google Scholar] [CrossRef]
- Wang, L.-Y.; Wang, M.-J. Removal of heavy metal ions by poly (vinyl alcohol) and carboxymethyl cellulose composite hydrogels prepared by a freeze–thaw method. ACS Sustain. Chem. Eng. 2016, 4, 2830–2837. [Google Scholar] [CrossRef]
- Yang, X.-H.; Yao, Y.-Q.; Huang, M.-H.; Chai, C.-P. Preparation and characterization of poly (vinyl alcohol)/ZIF-8 porous composites by ice-templating method with high ZIF-8 loading amount. Chin. J. Polym. Sci. 2020, 38, 638–643. [Google Scholar] [CrossRef]
- Wang, J.; Li, Y.; Lv, Z.; Xie, Y.; Shu, J.; Alsaedi, A.; Hayat, T.; Chen, C. Exploration of the adsorption performance and mechanism of zeolitic imidazolate framework-8@ graphene oxide for Pb (II) and 1-naphthylamine from aqueous solution. J. Colloid Interface Sci. 2019, 542, 410–420. [Google Scholar] [CrossRef]
- Shi, Z.; Yu, A.Y.; Fu, A.C.; Wanga, B.L.; Lia, X. Water-based synthesis of zeolitic imidazolate framework-8 for CO2 capture. RSC Adv. 2017, 7, 29227–29232. [Google Scholar] [CrossRef] [Green Version]
- Wijaya, C.J.; Ismadji, S.; Aparamarta, H.W.; Gunawan, S. Facile and Green Synthesis of Starfruit-Like ZIF-L, and Its Optimization Study. Molecules 2021, 26, 4416. [Google Scholar] [CrossRef]
- Fu, H.; Wang, Z.; Wang, X.; Wang, P.; Wang, C.C. Formation mechanism of rod-like ZIF-L and fast phase transformation from ZIF-L to ZIF-8 with morphology changes controlled by polyvinylpyrrolidone and ethanol. CrystEngComm 2018, 20, 1473–1477. [Google Scholar] [CrossRef]
- He, Y.; Zeng, L.; Feng, Z.; Zhang, Q.; Zhao, X.; Ge, S.; Hu, X.; Lin, H. Preparation, characterization, and photocatalytic activity of novel AgBr/ZIF-8 composites for water purification—ScienceDirect. Adv. Powder Technol. 2020, 31, 439–447. [Google Scholar] [CrossRef]
- Khan, I.U.; Othman, M.; Ismail, A.F.; Ismail, N.; Jaafar, J.; Hashim, H.; Rahman, M.A.; Jilani, A. Structural transition from two-dimensional ZIF-L to three-dimensional ZIF-8 nanoparticles in aqueous room temperature synthesis with improved CO2 adsorption. Mater. Charact. 2018, 136, 407–416. [Google Scholar] [CrossRef]
- Yao, X.; Zhu, G.; Zhu, P.; Ma, J.; Chen, W.; Liu, Z.; Kong, T. Omniphobic ZIF-8@Hydrogel Membrane by Microfluidic-Emulsion-Templating Method for Wound Healing. Adv. Funct. Mater. 2020, 30, 1909389. [Google Scholar] [CrossRef]
- Taheri, M.; Ashok, D.; Sen, T.; Enge, T.G.; Tsuzuki, T. Stability of ZIF-8 nanopowders in bacterial culture media and its implication for antibacterial properties. Chem. Eng. J. 2020, 413, 127511. [Google Scholar] [CrossRef]
- du Plessis, J.L.; Stefaniak, A.B.; Wilhelm, K.P. Measurement of Skin Surface pH. Curr. Probl. Dermatol. 2018, 54, 19–25. [Google Scholar] [PubMed]
- Yuan, S.; Zhu, J.; Li, Y.; Zhao, Y.; Li, J.; Van Puyvelde, P.; Bart, V.D.B. Structure architecture of micro/nanoscale ZIF-L on a 3D printed membrane for a superhydrophobic and underwater superoleophobic surface. J. Mater. Chem. A 2019, 7, 2723–2729. [Google Scholar] [CrossRef]
- Yin, X.; Mu, P.; Wang, Q.; Li, J. Superhydrophobic ZIF-8-Based Dual-Layer Coating for Enhanced Corrosion Protection of Mg Alloy. ACS Appl. Mater. Interfaces 2020, 12, 35453–35463. [Google Scholar] [CrossRef]
- Miao, W.; Wang, J.; Liu, J.; Zhang, Y. Zeolitic Imidazolate Framework: Self-Cleaning and Antibacterial Zeolitic Imidazolate Framework Coatings (Adv. Mater. Interfaces 14/2018). Adv. Mater. Interfaces 2018, 5, 1870068. [Google Scholar] [CrossRef] [Green Version]
- Wang, J.; Yu, S.; Yin, X.; Wang, L.; Zhu, G.; Wang, K.; Li, Q.; Li, J.; Yang, X. Fabrication of cross-like ZIF-L structures with water repellency and self-cleaning property via a simple in-situ growth strategy. Colloids Surf. A Physicochem. Eng. Asp. 2021, 623, 126731. [Google Scholar] [CrossRef]
- Bartlet, K.; Movafaghi, S.; Dasi, L.P.; Kota, A.K.; Popat, K.C. Antibacterial activity on superhydrophobic titania nanotube arrays. Colloids Surf. B-Biointerfaces 2018, 166, 179–186. [Google Scholar] [CrossRef]
- Xie, Y. Talking about active oxygen and human diseases. Mod. Agric. Sci. Technol. 2009, 285–286+288. [Google Scholar] [CrossRef]
- Yin, S. Environmental Microbiology; Academic Press: Cambridge, MA, USA, 2006. [Google Scholar]

Publisher’s Note: MDPI stays neutral with regard to jurisdictional claims in published maps and institutional affiliations. |
© 2022 by the authors. Licensee MDPI, Basel, Switzerland. This article is an open access article distributed under the terms and conditions of the Creative Commons Attribution (CC BY) license (https://creativecommons.org/licenses/by/4.0/).
Share and Cite
Yang, H.; Lan, X.; Xiong, Y. In Situ Growth of Zeolitic Imidazolate Framework-L in Macroporous PVA/CMC/PEG Composite Hydrogels with Synergistic Antibacterial and Rapid Hemostatic Functions for Wound Dressing. Gels 2022, 8, 279. https://doi.org/10.3390/gels8050279
Yang H, Lan X, Xiong Y. In Situ Growth of Zeolitic Imidazolate Framework-L in Macroporous PVA/CMC/PEG Composite Hydrogels with Synergistic Antibacterial and Rapid Hemostatic Functions for Wound Dressing. Gels. 2022; 8(5):279. https://doi.org/10.3390/gels8050279
Chicago/Turabian StyleYang, Hang, Xianyu Lan, and Yuzhu Xiong. 2022. "In Situ Growth of Zeolitic Imidazolate Framework-L in Macroporous PVA/CMC/PEG Composite Hydrogels with Synergistic Antibacterial and Rapid Hemostatic Functions for Wound Dressing" Gels 8, no. 5: 279. https://doi.org/10.3390/gels8050279
APA StyleYang, H., Lan, X., & Xiong, Y. (2022). In Situ Growth of Zeolitic Imidazolate Framework-L in Macroporous PVA/CMC/PEG Composite Hydrogels with Synergistic Antibacterial and Rapid Hemostatic Functions for Wound Dressing. Gels, 8(5), 279. https://doi.org/10.3390/gels8050279

